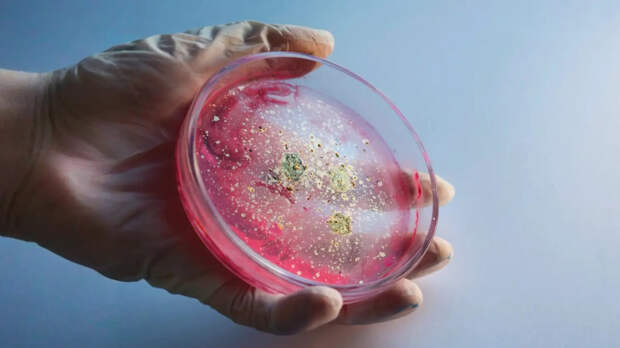
Как микробиом кишечника влияет на тело и психику: разобрались по науке

На информационном ресурсе применяются рекомендательные технологии (информационные технологии предоставления информации на основе сбора, систематизации и анализа сведений, относящихся к предпочтениям пользователей сети "Интернет", находящихся на территории Российской Федерации)